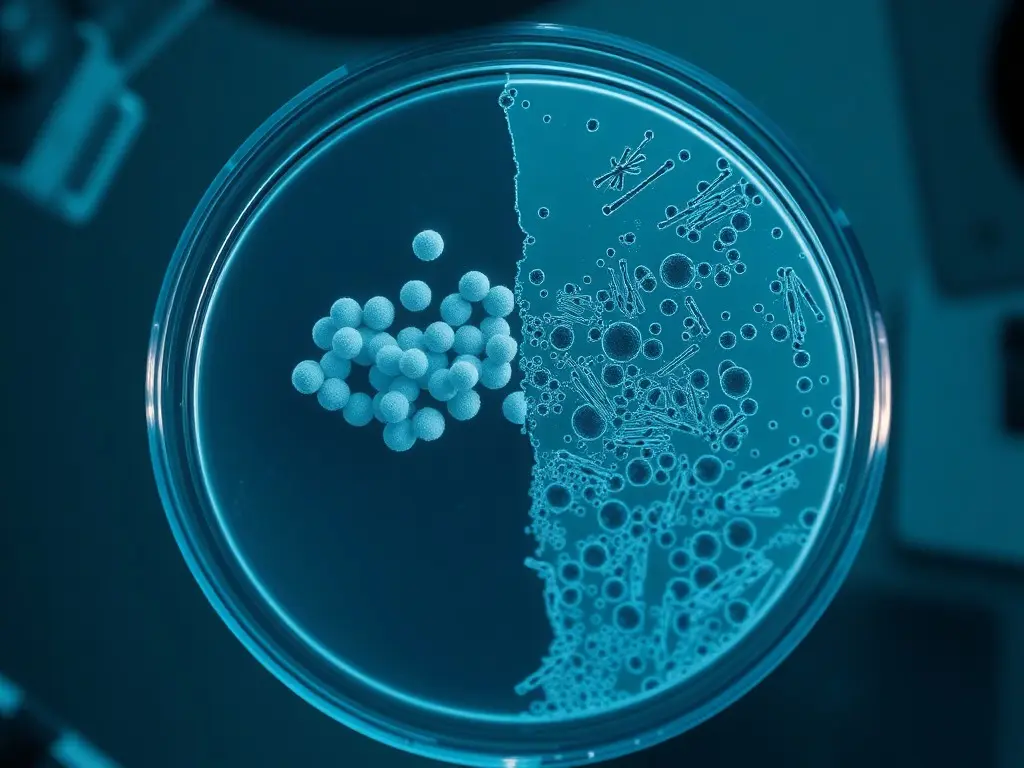
Revolutionizing Antibacterial Treatments: The Promising Role of Graphene Against Superbugs

Revolutionizing Antibacterial Treatments: The Promising Role of Graphene Against Superbugs
Researchers from The Korea Advanced Institute of Science and Technology (KAIST) have discovered that graphene has antibacterial properties, effectively eliminating superbugs while leaving human cells unharmed. The study was published on April 26, 2026, and represents a significant advancement in the battle against antibiotic-resistant infections.
Researchers from The Korea Advanced Institute of Science and Technology (KAIST) published a study on April 26, 2026, revealing graphene's antibacterial properties. Graphene effectively eliminates superbugs, a growing global health threat, while sparing human cells. The material's unique structure allows it to physically damage bacterial cell membranes and produce reactive oxygen species toxic to bacteria. KAIST's experiments included in vitro and in vivo tests, demonstrating graphene's selective antibacterial effect. Graphene's properties make it suitable for medical coatings to prevent bacterial infections on surfaces. The discovery presents a new avenue for developing treatments against antibiotic-resistant infections.
This content was automatically generated and/or translated by AI. It may contain inaccuracies. Please refer to the original sources for verification.